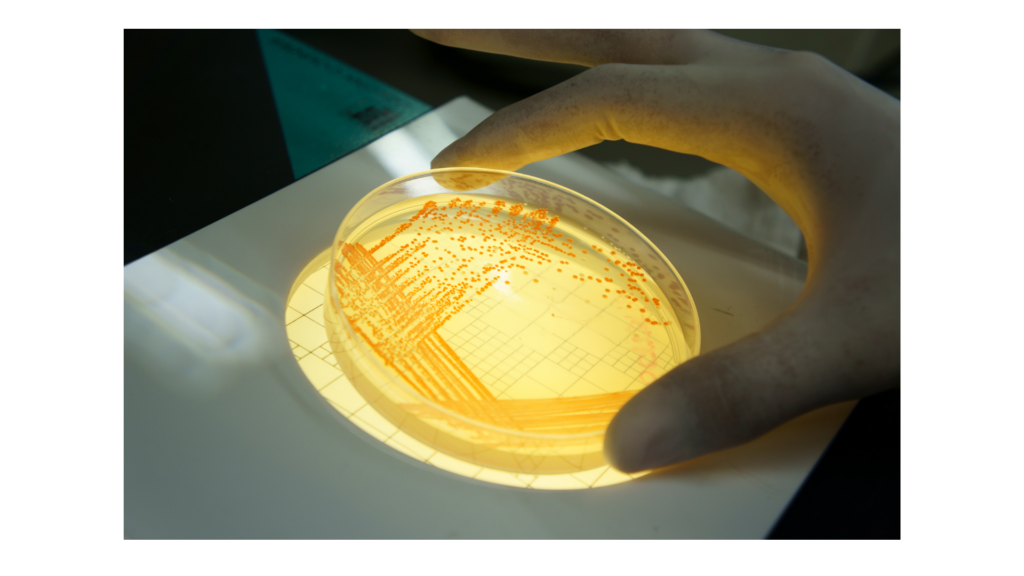
Clasificación de los biocidas

The biocides son sustancias o mezclas destinadas a controlar organismos nocivos como plagas, hongos o bacterias. Su uso es fundamental en sectores como la agroganadería, la industria alimentaria o el control ambiental, pero está fuertemente regulado.
En este artículo, repasamos los principales tipos de biocidas y los requisitos básicos para su aplicación profesional.
Clasificación de los biocidas
Según la normativa europea, los biocidas se agrupan en tipos de producto (TP) en función de su uso previsto, por ejemplo:
- TP 3: higiene veterinaria.
- TP 4: desinfección de superficies en contacto con alimentos y piensos.
- TP 18: insecticidas.
- TP 19: repelentes y atrayentes.
Cada categoría tiene requisitos específicos en cuanto a evaluación, autorización y etiquetado.
Normativa aplicable y autorizaciones
El uso de biocides está regulado por:
- El Reglamento (UE) sobre productos biocidas.
- Normativa nacional complementaria.
Los productos deben estar autorizados y cumplir con exigentes evaluaciones de seguridad y eficacia. Además, las empresas aplicadoras necesitan:
- Personal formado y acreditado.
- Procedimientos internos de seguridad y registro de tratamientos.